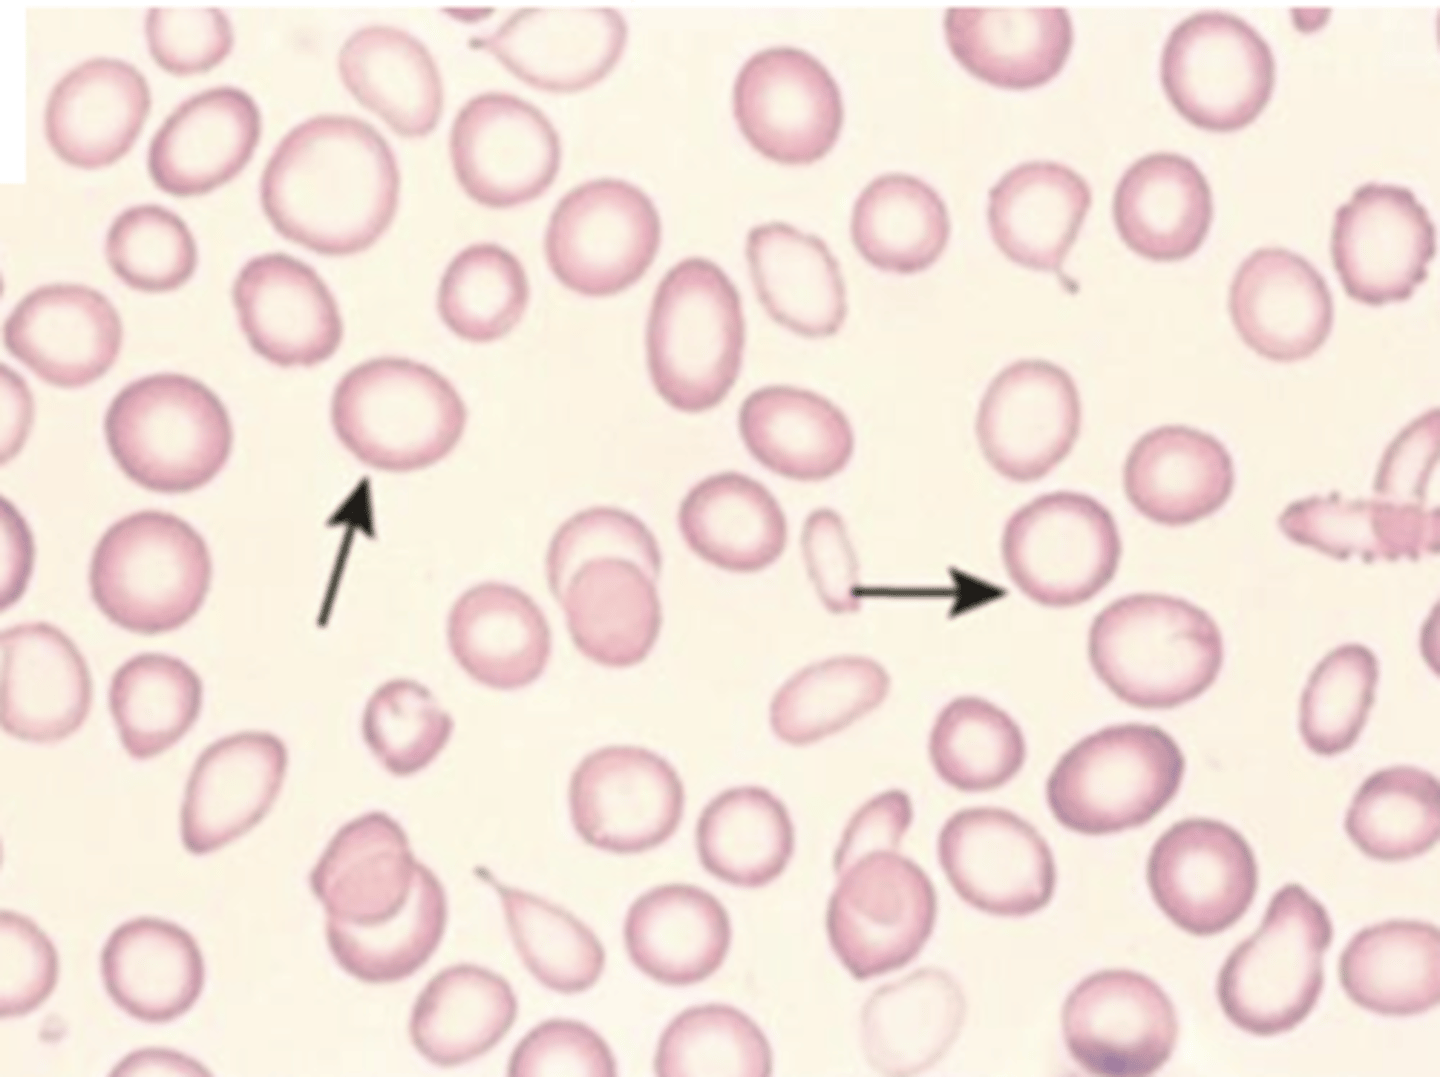
<p>decrease MCHC</p>
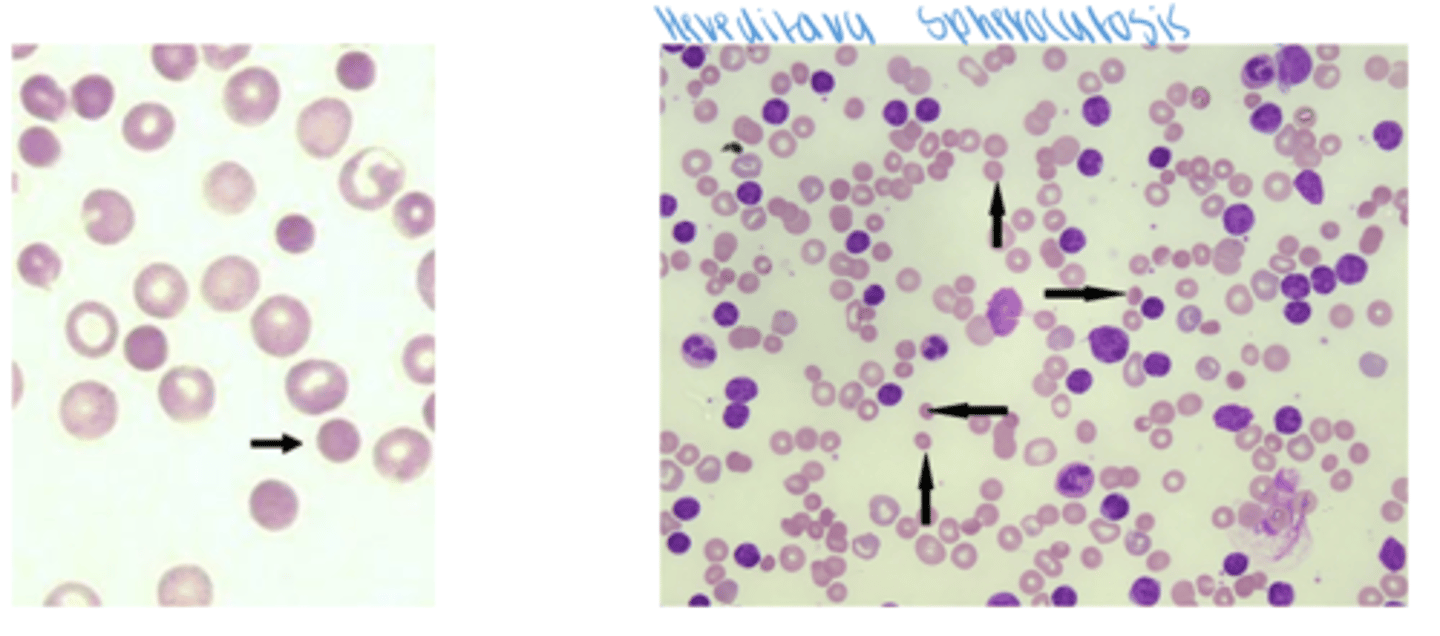
<p>*lack of central pallor</p><p>increase MCHC</p>
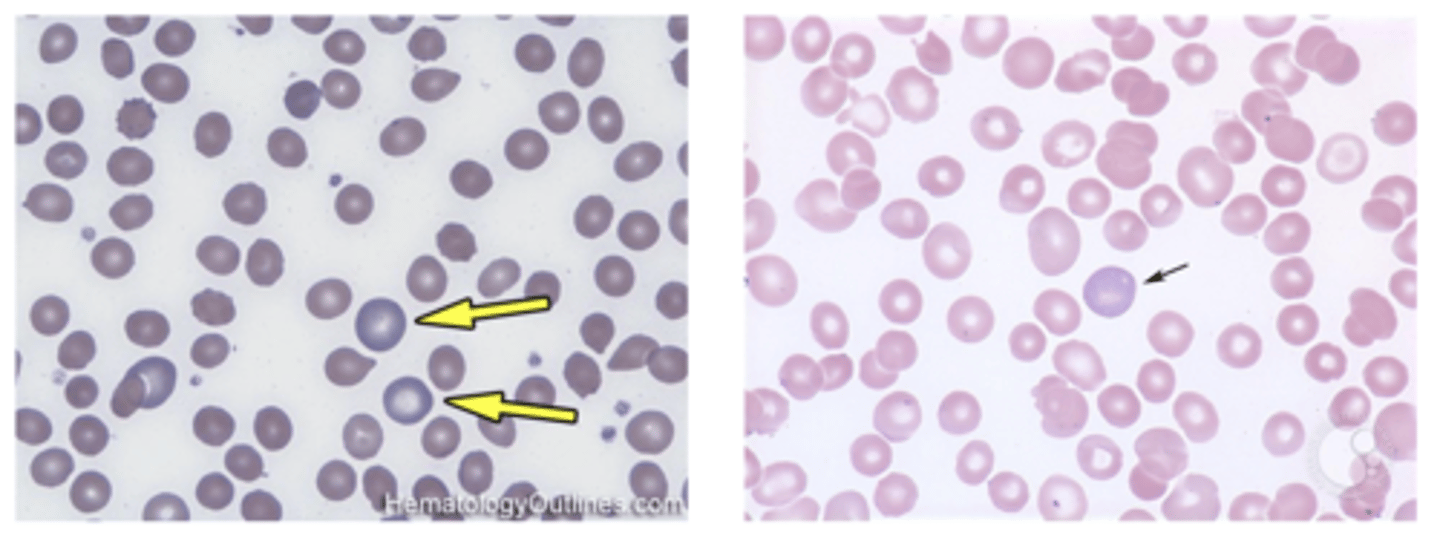
knowt flashcard image
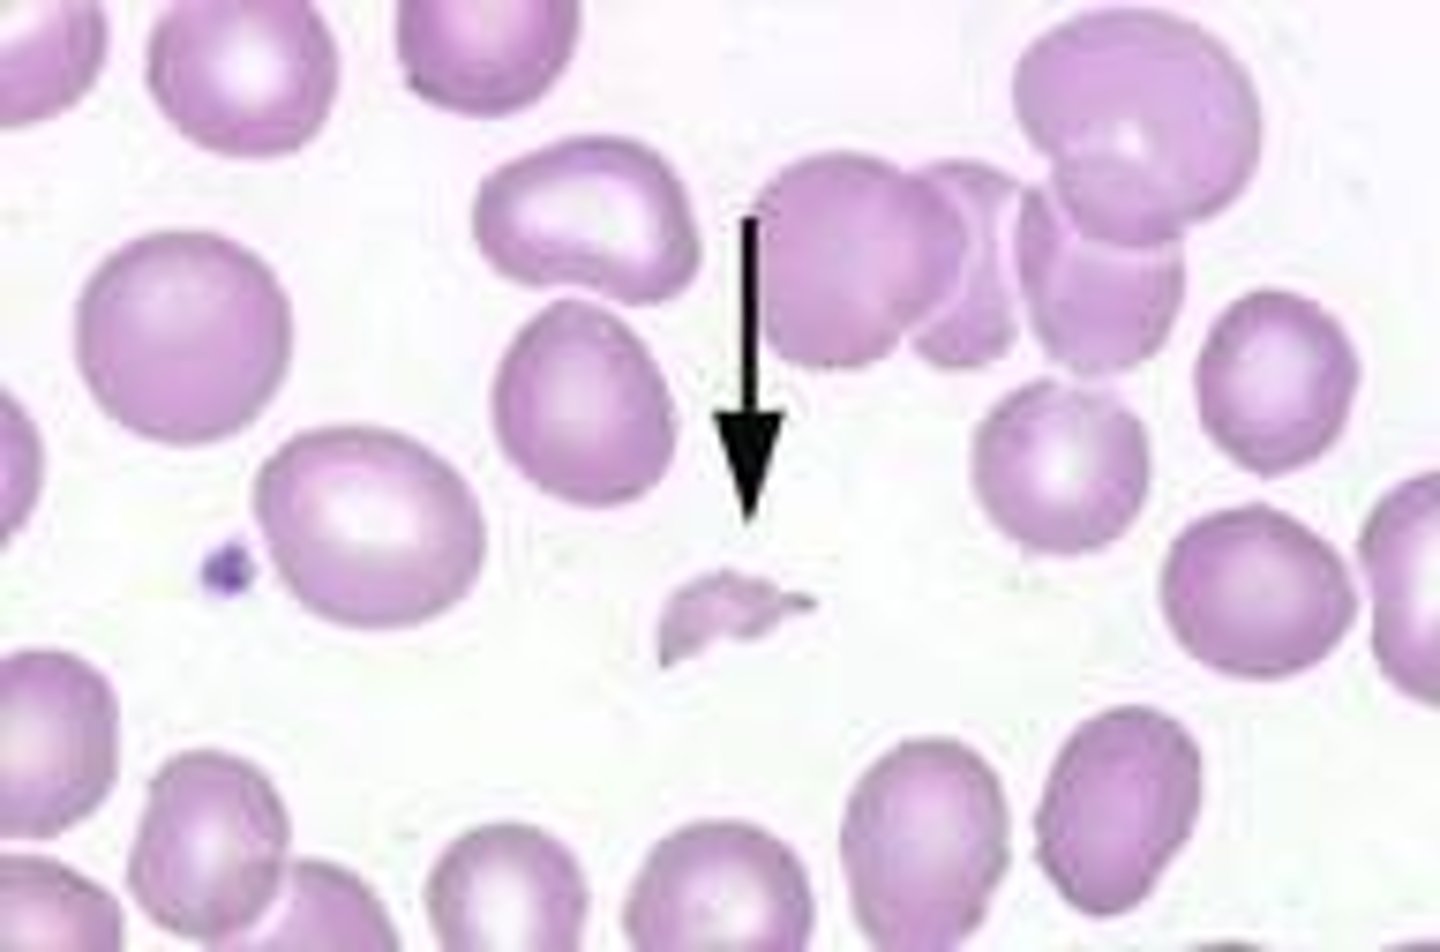
<p>- traumatic hemolytic</p>
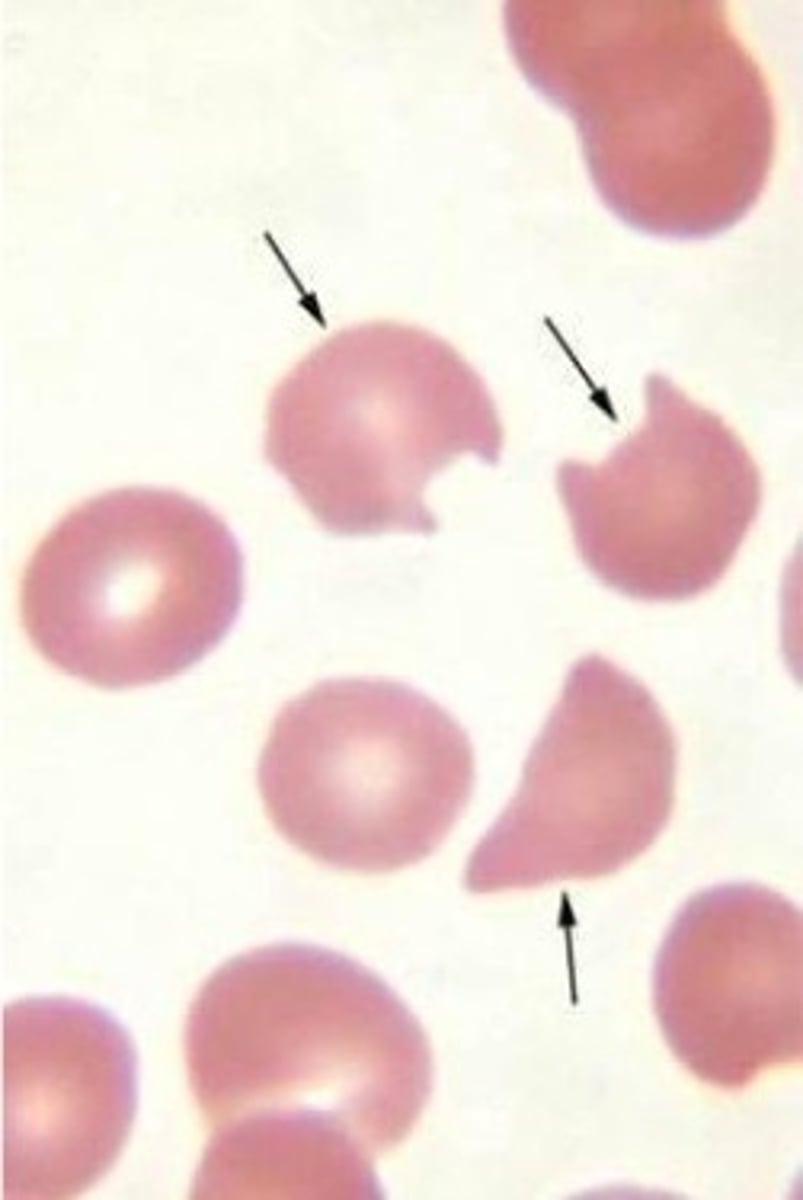
<p>- G6PD anemia</p>
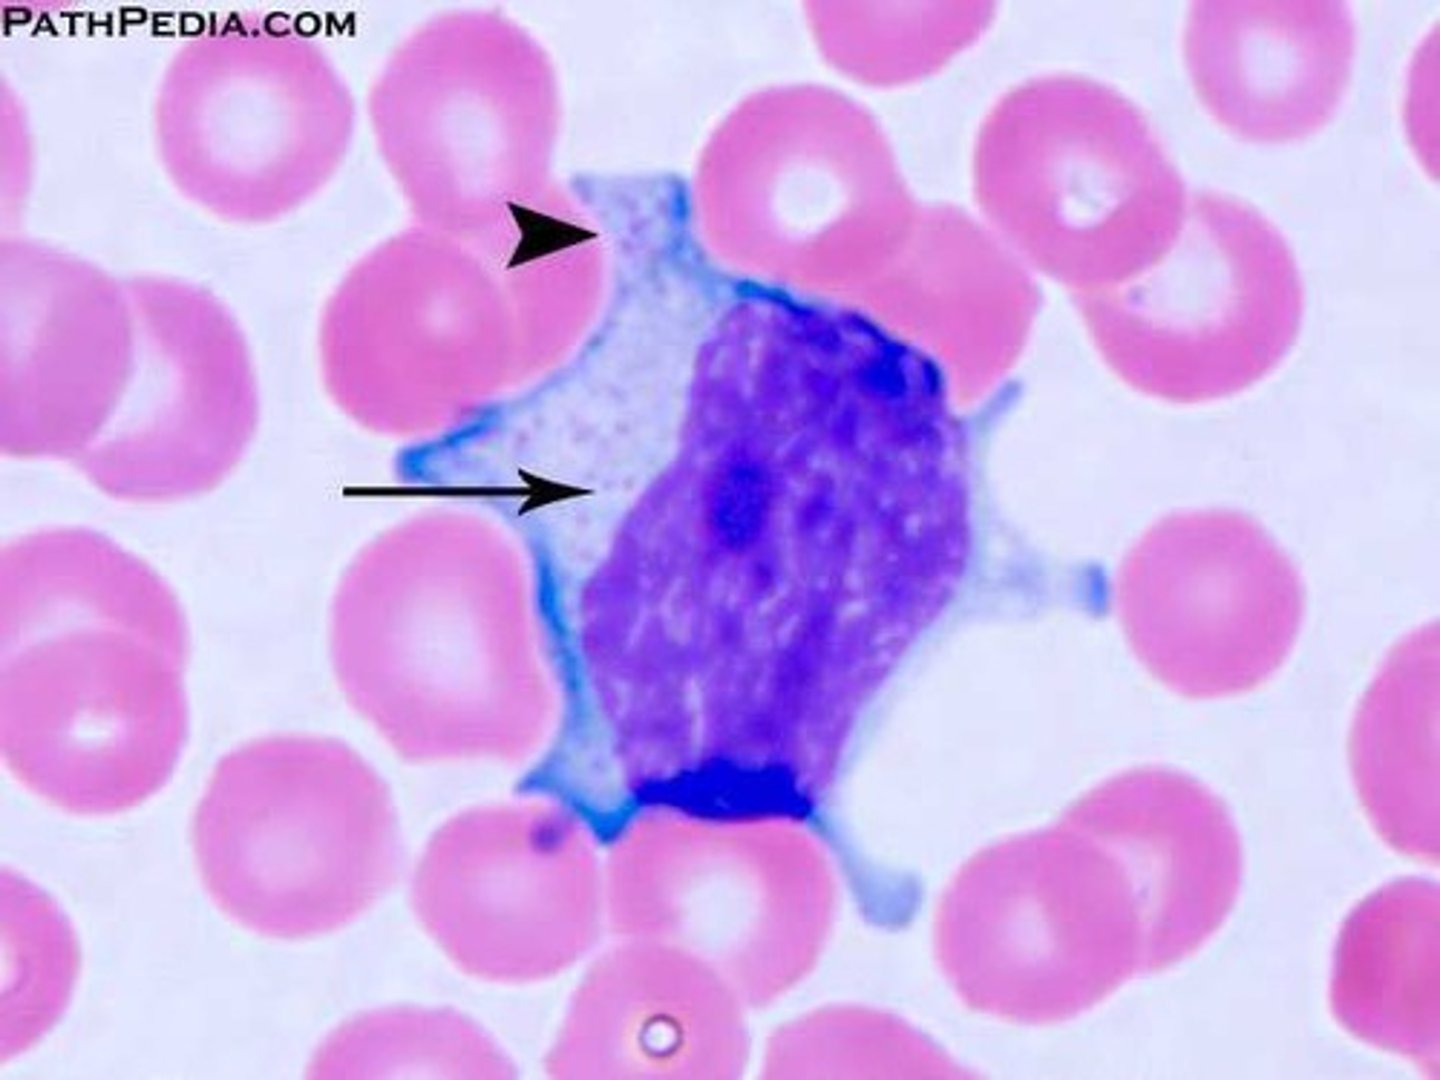
<p>acute viral infection</p>

1/89
Looks like no tags are added yet.
Name | Mastery | Learn | Test | Matching | Spaced | Call with Kai |
|---|
No analytics yet
Send a link to your students to track their progress
Hematopoiesis - Sites of Blood Cell Production
- First trimester - ___ ___
- Second trimester - ____, _____
- Third trimester - ____ ____
- Birth to 20 - _____, _____
- Age 20 - _____, ______, ______
- First trimester - yolk sac
- Second trimester - liver, spleen
- Third trimester - bone marrow
- Birth to 20 - tibia, femur
- Age 20 - vertebra, sternum, ribs
Hb F =
(alpha 2; gamma 2) - 0.5%
Hb A
(alpha 2, beta 2) - 95-98%
Hb A2
(alpha 2, delta 2) - 1.5-2.5%
heme =
porphyrin + iron
globin =
two pairs of polypeptide chains
hemoglobin derivatives =
deoxyhemoglobin, oxyhemoglobin, carboxyhemoglobin
the following statements describe ___
• Affinity of hemoglobin for CO is 210X greater than for O2
• ↑ smokers, tax drivers
carboxyhemoglobin (really bright red)
lifespan of an RBC
120 days
(don't get caught not knowing)
extravascular hemolysis = ____ %
90%
- spleen, liver, lymph nodes
if anemia is present what is the best test to do
hemoglobin
decrease Hb =
anemia
increase Hb =
erythrocytosis
why do a Hb test
respiratory protein of RBC, detecting anemia or erythrocytosis
Causes for erythrocytosis
high altitude, lung/cardiac conditions, polycythemia veracity, dehydration
Hb test limitations
- tourniquet on too long (>1 min)
- dehydration
Hb references ranges
women:
men:
anemia women:
anemia men:
women: 14.0 g/dL +/-2
men: 16.0 g/dL +/- 2
anemia women: < 11 g/dL
anemia men: 13.0 g/dL
increased RBCs =
erythrocytosis
decreased RBCs =
anemia
total RBC count reference range
women:
men:
women: 3.5-5.5 million/mL
men: 4.3-5.9 million/mL
the following statements describe _____
• Ratio of spun RBCs to plasma
• Abnormalities in Hct parallel those for Hb
hematocrit
hematocrit reference range
women:
men:
women: 37-47%
men: 40-54%
limitations of hematocrit
similar to Hb
- Hb x 3 = Hct
RBC indices
• Determine morphologic type of anemia
• RBC count, hemoglobin, and hematocrit used to calculate indices
• MCV, MCH, MCHC, MPV, RDW
Mean Corpuscular Volume (MCV) =
MCV = Hct/ RBC count
MCV reference range
80-100
Mean Corpuscular Hemoglobin
(MCH)
increased =
decreased =
increased = macrocytic anemias
decreased = microcytic and normocytic anemias
MCH reference range
27-33 pg
Mean Corpuscular Hemoglobin
Concentration (MCHC) =
hemoglobin/hematocrit
- average concentration of Hb in the average RBC
MCHC reference range
32-36 g/dL
earliest indicator of the potential for anemia
Red Blood Cell Distribution
Width (RDW)
Red Blood Cell Distribution
Width (RDW) =
distribution of individual RBC volume
Red Blood Cell Distribution
Width (RDW) reference range
11-15%
RDW is never ___
decreased
_____ is best for determining morphological type of anemia
PBS
abnormality in RBC size =
anisocytosis
- microcytosis <80
- macrocytosis >100
macrocytosis causes
- B12/folate deficiency
- liver disease
- alcoholism
- myxedema
- reticulocytosis
microcytosis causes
- IDA
- thalassemia
- anemia of chronic disease
- sideroblastic anemia
hypochromatic image
decrease MCHC
hyperchromatic image
*lack of central pallor
increase MCHC
polychromatic reticulocytes
WBC count reference range
4500-11000/mL
leukopenia
- viral
decrease in WBC count
leukocytosis
increase WBC count
- bacteria
- general inflammation
neutrophils normal range
50-70%
elevation of neutrophils =
neutrophilia
neutrophilia causes
physiologic:
pathologic:
physiologic: stress
pathologic: acute bacterial infection & general inflammation
decrease in neutrophils =
neutropenia
- viral

lymphocytes normal range
20-40%

lymphocytes elevations
lymphocytosis
- viral infection
lymphocytes decrease
lymphocytopenia/lymphopenia
- bacterial infection
monocytes normal range
2-10%

elevation in monocytes
monocytosis
- good sign, recovery from infection
eosinophils normal range
1-5%
eosinophils elevation
eosinophilia
- allergies (6-10%)
- parasite (25-30%)
- malignancies

basophils normal range
0-1%

basophils elevation
basophilia
- hypersensitivity reactions
- myxedema
- myeloproliferative conditions
platelet count reference range
150000-400000
increased platelets
thrombocythemia aka thrombocytosis
*malignancy
thrombocytopenia =
<70,000 clinically evident bleeding tendency
why would you do a reticulocyte count
• Count of immature RBCs w/o
nuclei
• Estimate rate of RBC
production
• Increased reticulocyte count
- increased number of RBCs
put into peripheral blood in
response to some stimulus
what test is good for monitoring treatment of anemia
reticulocyte count
reticulocyte count reference range
0.5-1.5%
MCC of reticulocytosis increase =
- hemolytic anemia
- acute bleeding
- after treatment of anemia
causes of decreased reticulocytes
- conditions w/inadequate hematopoiesis
- bone marrow failure
- lack of EPO (renal disease)
mean platelet volume (MPV)
- size of platelets
- ordered alongside platelet count
elevated MPV =
myeloproliferative disorders, cancers, cardiovascular disease
low MPV =
aplastic anemia
erythrocyte sedimentation rate (ESR)
• Aid in detecting inflammatory
conditions
- distance/time
Factors that ↑ ESR:
Plasma proteins - fibrinogen, immunoglobulins
limitations of ESR
• Non-specific test
• Can sometimes remain normal when it should not be
• Anemias can increase or decrease
• Poikilocytosis (abnormal shape RBC) will falsely decrease ESR
if the ESR is >100
- immediate action
- labs & imaging
if ESR is 50-100 it is
history dependent
ESR reference range
males under 40:
women under 40:
males under 40: 1-15 mm/hr
women under 40: 1-20 mm/hr
ESR formula for maximum NL at a given age
Males = Age/2
Females = Age + 10/2
accelerate ESR could indicate
• Bacterial infections
• Severe anemia
• Leukemia
• Lymphoma
• Metastatic tumor
• Multiple myeloma
• Ulcerative colitis
• Acute pancreatitis
• Cholecystitis
• Rheumatic fever
• Lupus erythematosus
• Scleroderma
• Acute glomerulonephritis
• Pyelonephritis
• Inflammatory arthritis
• Inflammation
• Hypothyroidism
• Surgery
• Pregnancy
C-Reactive Protein (CRP)
• Acute phase reactant
• Virtually absent from serum of healthy person
• One of the most sensitive acute phase reactants
• Begins to rise 4-6 hours after onset of inflammation
• Half life: 5-7 hours
is CRP better for chronic or acute
acute
elevated CRP could indicate
• Bacterial infections
• Severe anemia
• Leukemia
• Lymphoma
• Metastatic tumor
• Multiple myeloma
• Ulcerative colitis
• Acute pancreatitis
• Cholecystitis
• Rheumatic fever
• Lupus erythematosus
• Scleroderma
• Acute glomerulonephritis
• Pyelonephritis
• Inflammatory arthritis
• Inflammation
• Hypothyroidism
• Surgery
• Pregnancy
CRP =
- no interference from anemia or serum protein changes
- more sensitive
- response to care
ESR =
chronic inflammatory
spherocytes
- hereditary spherocytosis
- increase MCHC

schistocyte
- traumatic hemolytic
bite cell
- G6PD anemia
sickle cells

tear drop cell
- myeloproliferative disease
- leukemias

rouleaux
- inflammation (fibrinogen)

codocyte (target cell)
- thalassemia

what does > 5 nuclear lobes for neutrophils indicate
= B12/folate deficiency
reactive lymphocyte
acute viral infection